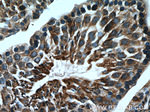
LDHC Antibody in Immunohistochemistry (Paraffin) (IHC (P))
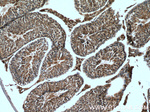
LDHC Antibody in Immunohistochemistry (Paraffin) (IHC (P))
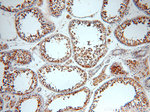
LDHC Antibody in Immunohistochemistry (Paraffin) (IHC (P))

Search
Proteintech
LDHC Polyclonal Antibody
{{$productOrderCtrl.translations['antibody.pdp.commerceCard.promotion.promotions']}}
{{$productOrderCtrl.translations['antibody.pdp.commerceCard.promotion.viewpromo']}}
{{$productOrderCtrl.translations['antibody.pdp.commerceCard.promotion.promocode']}}: {{promo.promoCode}} {{promo.promoTitle}} {{promo.promoDescription}}. {{$productOrderCtrl.translations['antibody.pdp.commerceCard.promotion.learnmore']}}
产品信息
19989-1-AP
种属反应
宿主/亚型
分类
类型
抗原
偶联物
形式
浓度
规格
纯化类型
保存液
内含物
保存条件
运输条件
产品详细信息
The antibody has no cross reaction with LDHA and LDHB.
靶标信息
Lactate dehydrogenase C catalyzes the conversion of L-lactate and NAD to pyruvate and NADH in the final step of anaerobic glycolysis. LDHC is testis-specific and belongs to the lactate dehydrogenase family. Two transcript variants have been detected which differ in the 5' untranslated region.
仅用于科研。不用于诊断过程。未经明确授权不得转售。
生物信息学
蛋白别名: Cancer/testis antigen 32; CT32; L-lactate dehydrogenase C chain; lactate dehydrogenase (E.C. 1.1.1.27); lactate dehydrogenase 3, C chain, sperm specific; lactate dehydrogenase C4; lactate dehydrogenase-X; LDH testis subunit; LDH-C; LDH-C4; LDH-X; MGC111073; testis secretory sperm-binding protein Li 234P
基因别名: CT32; Ldh-3; LDH-C4; Ldh-x; LDH3; LDHC; Ldhc4; LDHX
UniProt ID: (Human) P07864, (Mouse) P00342
Entrez Gene ID: (Human) 3948, (Mouse) 16833